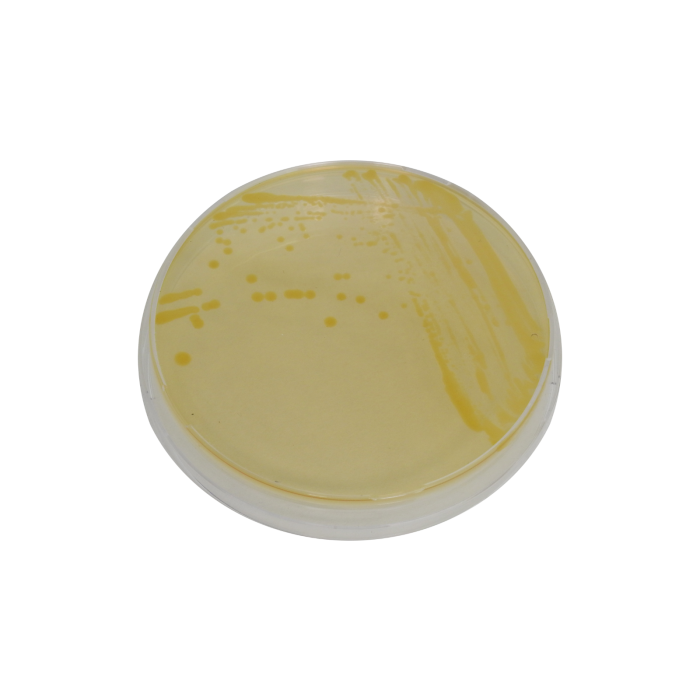
main product photo

Pectobacterium polaris Pure Culture
€ 368.00
In stock
SKU
Ppol_Culture
Pectobacterium polaris inoculum
Any questions?
On request we’re able to customize our products for your specific purpose. Please contact us via primediagnostics@wur.nl.
Pectobacterium polaris inoculum